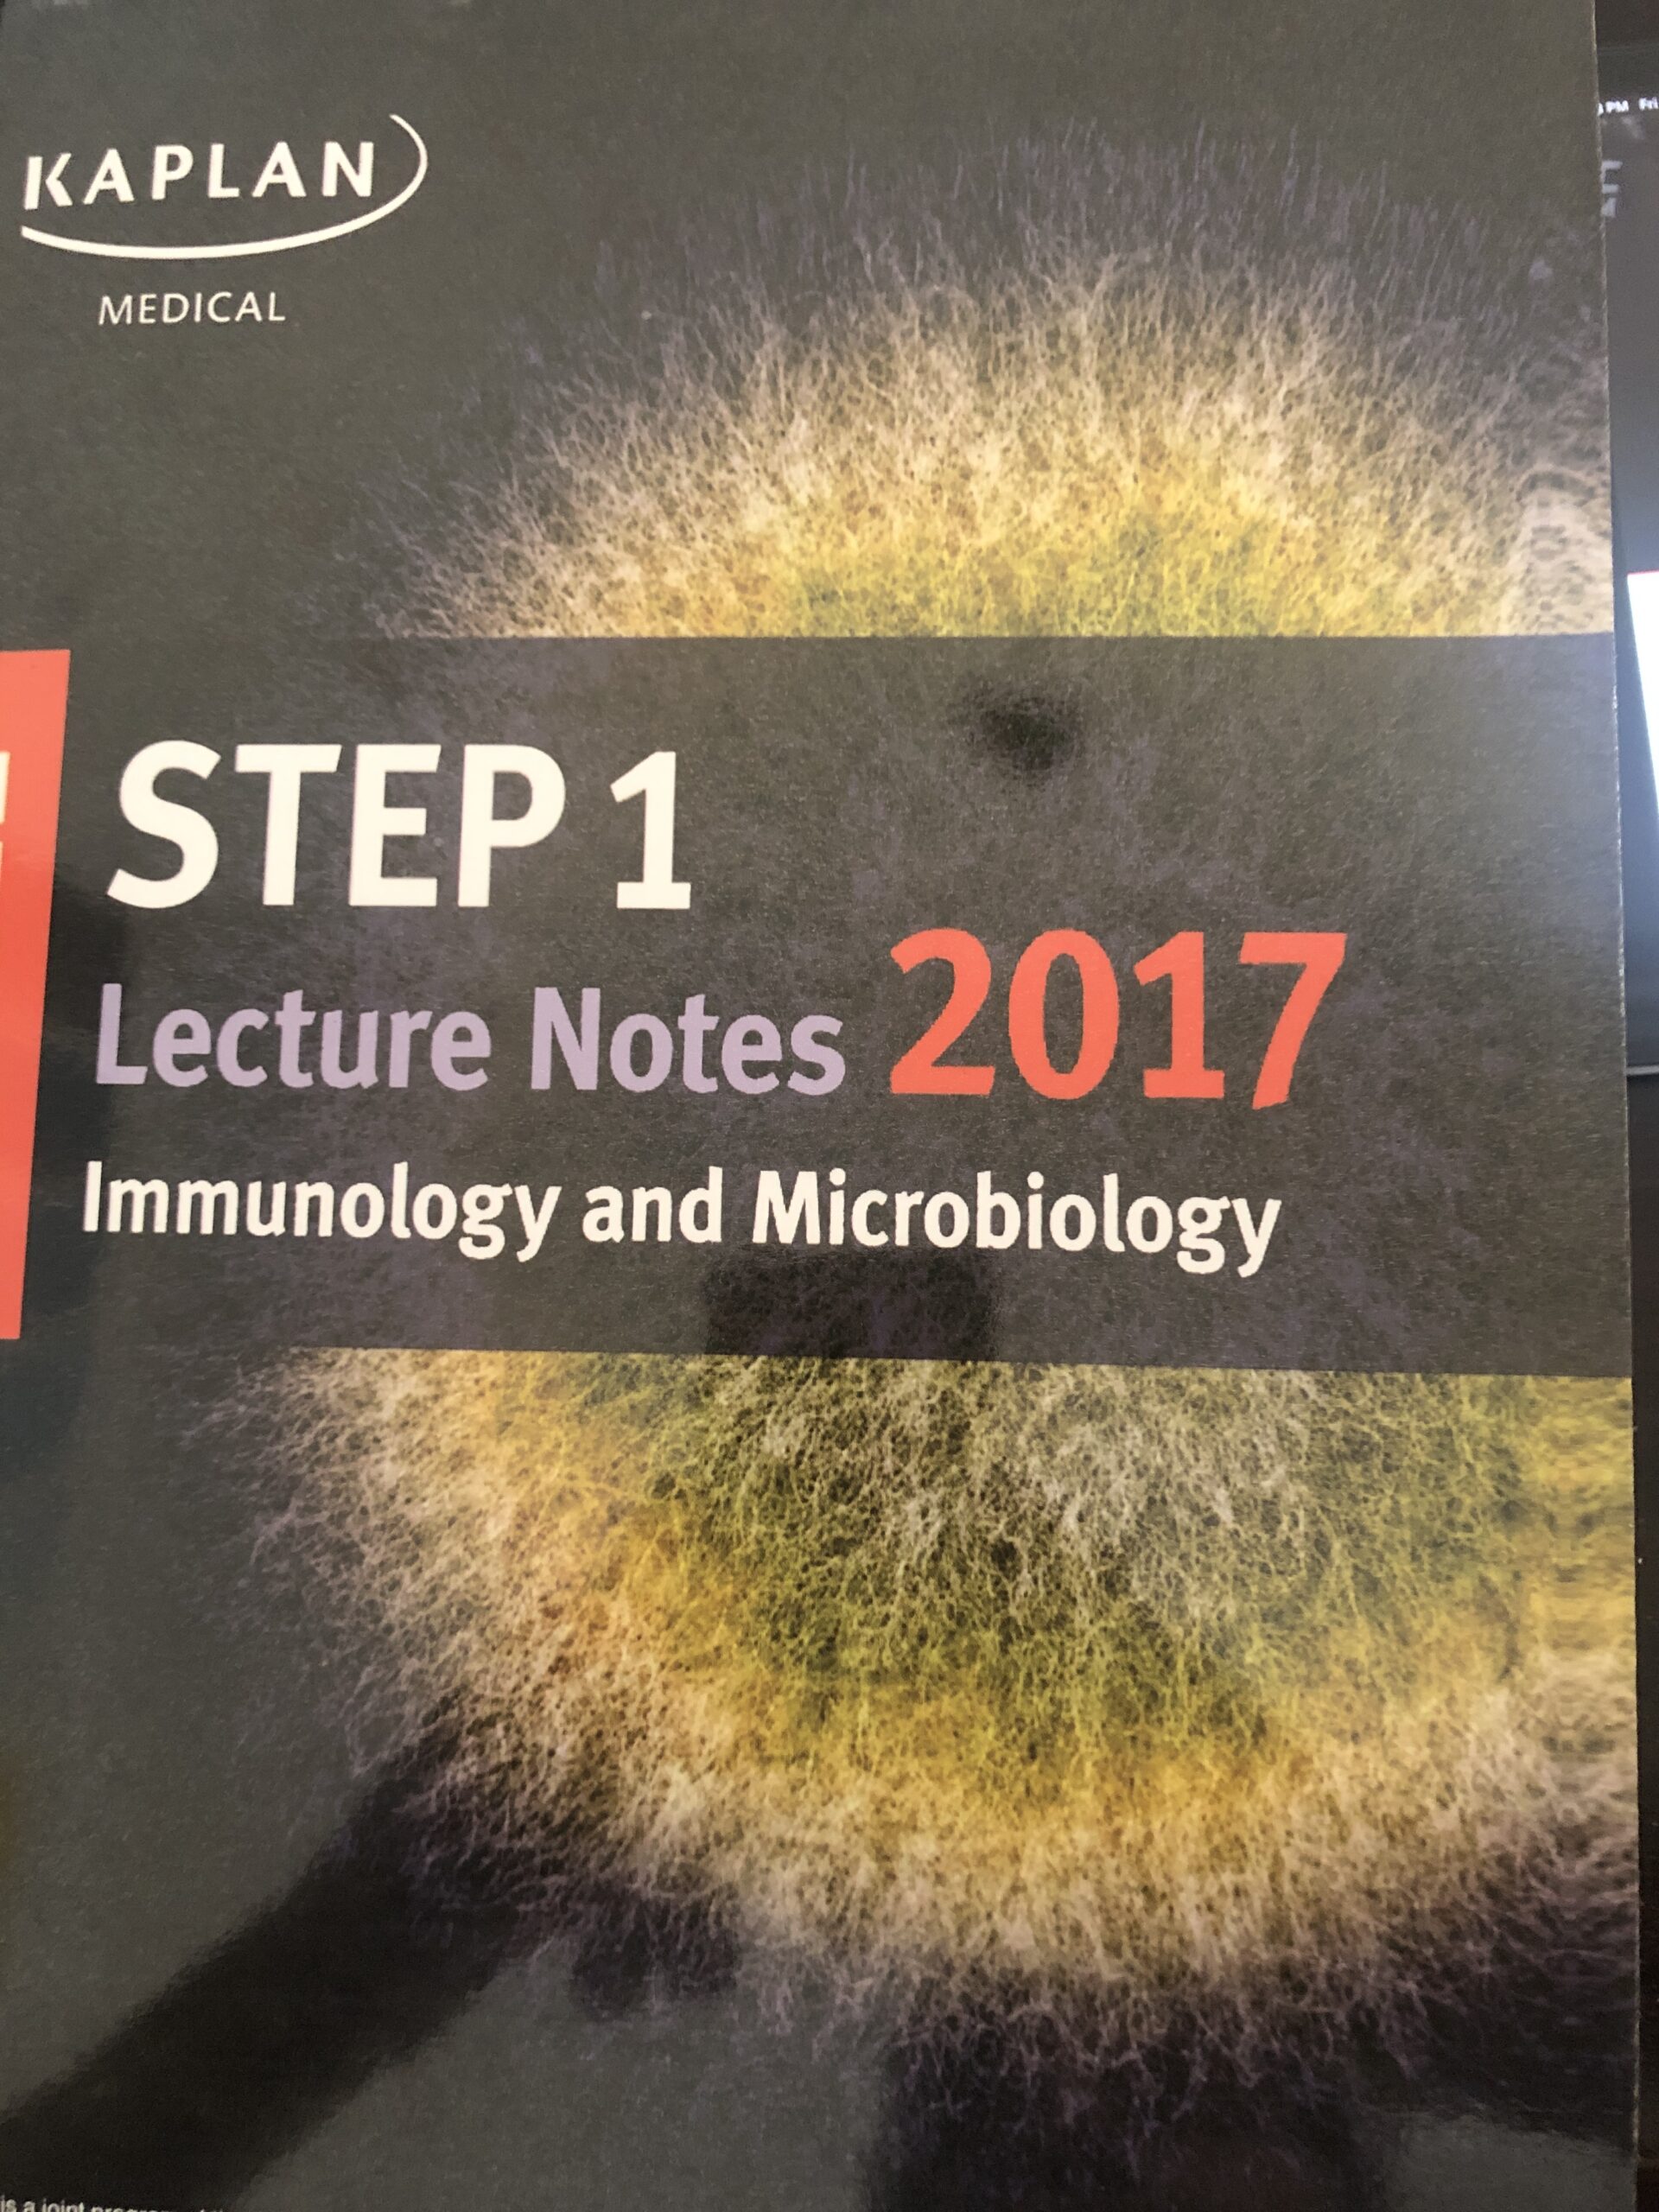

This website is designed to help you find the best prices for products in Jordan. It's a specialized platform that lets you easily search for product prices in the market. Just type the name or number of the product you're looking for in the search box above, hit the search button, and we'll display the results sorted by the best price.